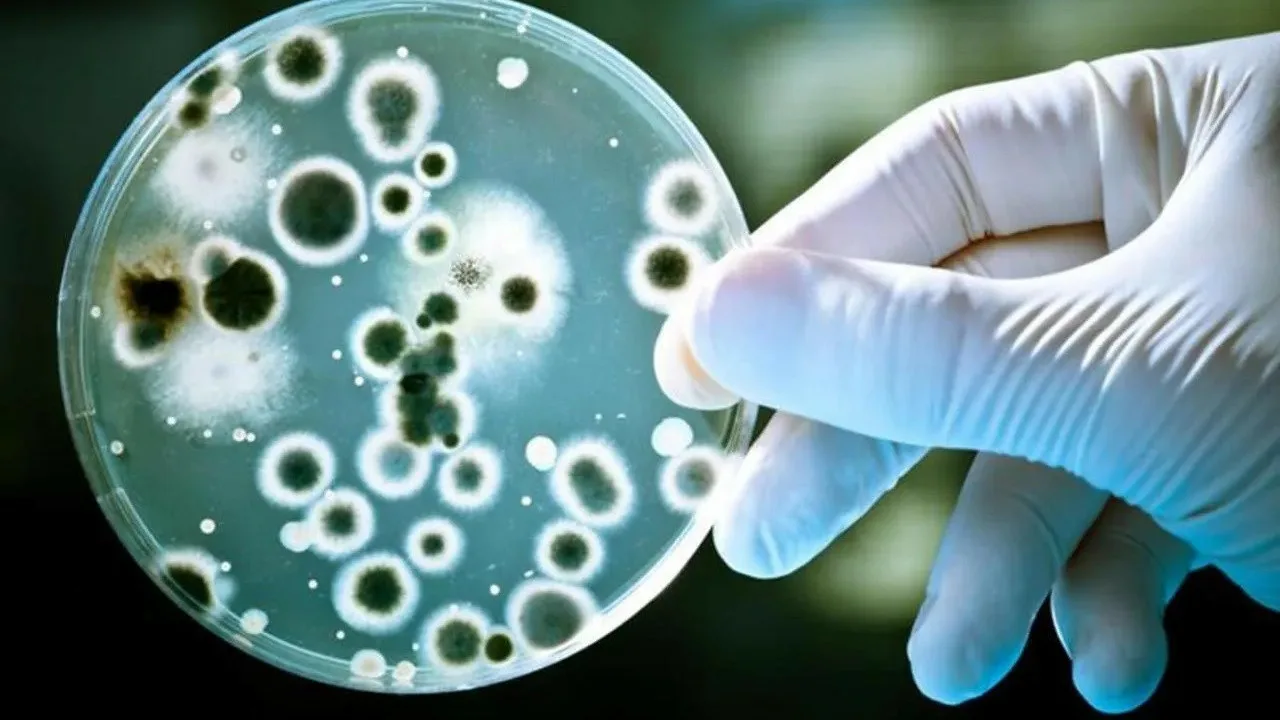
Tutkijat eivät voi uskoa sitä: he ovat löytäneet tuhansia uusia mikro-organismilajeja eri kasvinsyöjien ulosteista.

Ryhmä tutkijoita Qinghai-Tiibetin ylängöllä on löytänyt hämmästyttävän ”mikrobien universumin” paikallisten suurten kasvinsyöjien ulosteista.
Sisällysluettelo
Julkaistu tutkimus osoitti, että lähes 88 % jakkien, tiibetiläisten lampaiden, antilooppien, suurten nautojen, hevosten ja kiangien ulosteista löydetyistä mikro-organismilajeista ei ollut aiemmin luokiteltu. Tämä löytö avaa uusia mahdollisuuksia bioteknologiassa, farmakologiassa ja ilmastonmuutoksen torjunnassa.

Qinghai-Tiibetin ylängöllä laiduntavien eläinten ulosteista on löydetty lukuisia uusia mikro-organismilajeja.
Löytö on osa toista tieteellistä tutkimusretkeä ja tutkimusohjelmaa Tiibetin ylängöllä, jonka aikana viiden vuoden aikana kerättiin yli 5000 ulostenäytettä kuudelta paikalliselta kasvinsyöjältä: jakeilta, tiibetiläisiltä lampaita, antiloopeilta, suurilta sarvipäisiltä, hevosilta ja kiangeilta (villiaaseilta).
BGI-Research-yhtiön ja Yunnanin yliopiston asiantuntijoiden tekemä alustava analyysi keskittyi 1412 tuoreeseen näytteeseen. Tulokset ylittivät odotukset: noin 88 % ulosteista löydetyistä mikro-organismilajeista ei ollut aiemmin luokiteltu.
Tutkimuksen pääkirjoittaja Zhang Zhigang korosti South China Morning Post (SCMP) -lehdelle antamassaan haastattelussa, että tämä mikrobien tietokanta antaa ensimmäistä kertaa kattavan kuvan korkealla vuoristossa elävien nisäkkäiden suolistomikrobiomista.
Lisäksi hän korosti tämän löydön strategista merkitystä, koska monet näistä biologisista toiminnoista voivat tulla patentoitaviksi voimavaroiksi kasvavan globaalin kilpailun vuoksi genomiresursseista.

Ruohonsyöjien ulosteissa esiintyvät mikro-organismit, joilla on bioteknologista potentiaalia ja mahdollisuuksia teolliseen käyttöön.
Ekologisen merkityksensä lisäksi ulosteista löydetyt mikro-organismit ovat lupaava innovaatioiden lähde geenitekniikassa ja farmakologiassa.
Tutkijat ovat havainneet, että uusien löydettyjen geenien joukossa voi olla entsyymejä, joiden toiminnot ovat samanlaisia kuin CRISPR-Cas-järjestelmän, joka on avainasemassa DNA:n tarkassa leikkaamisessa ja muokkaamisessa. Mahdollisuus löytää vakaampia tai tehokkaampia vaihtoehtoja avaa näkymiä geenien muokkaustekniikoiden parantamiseen.
SCMP:n mukaan farmaseuttisella alalla löydettyjen mikro-organismien monimuotoisuus sisältää molekyylejä, joista voi tulla uusia mikrobilääkkeitä tai terapeuttisia aineita.
Vaikutus ympäristöön: uudet mikrobiset reitit kasvinsyöjien ulosteissa, jotka edistävät metaanipäästöjen vähentämistä ja selluloosan hajoamista.
Hanke esittelee myös havainnollisia esimerkkejä korkealla elävien kasvinsyöjien mikrobiomin käytöstä kasvihuonekaasupäästöjen vähentämiseksi . Tässä on joitakin merkittävimpiä esimerkkejä:
- Tehokas selluloosan hajoaminen: kasvinsyöjät syövät kuitupitoisia kasveja, mikä edistää selluloosan hajoamiseen erikoistuneiden entsyymien tuotantoa. Tiimi tutkii, voidaanko näitä kantoja käyttää esimerkiksi paperin tai tekstiilien tuotannossa.
- Bakteerit, jotka vähentävät metaanipäästöjä: Tutkimuksen aikana löydettiin kaksi aiemmin tuntematonta bakteerilajia ulosteesta, jotka vähensivät metaanipäästöjä merkittävästi verrattuna kontrolliryhmään in vitro -fermentaatiotesteissä. Tutkijat valmistelevat parhaillaan kokeita näiden tulosten vahvistamiseksi eläimillä.
Tämä löytö voi tehdä Qinghai-Tiibetin ylängöstä maailmanlaajuisen esikuvan biologisten ratkaisujen kehittämiselle ilmastonmuutoksen torjumiseksi.
Alueella, jossa vain erittäin sopeutumiskykyiset organismit voivat menestyä, tutkijat ovat löytäneet toiminnallisen reservin, joka voi tulevaisuudessa muuttaa bioteknologian ja teollisuuden.
